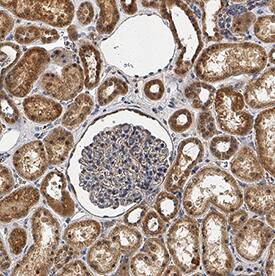
RIPK4/RIP4 antibody in Human Kidney by Immunohistochemistry (IHC-P).

Human/Mouse RIPK4/RIP4 Antibody
R&D Systems, part of Bio-Techne | Catalog # AF10002


Key Product Details
Species Reactivity
Applications
Label
Antibody Source
Product Specifications
Immunogen
Thr218-Thr450
Accession # P57078
Specificity
Clonality
Host
Isotype
Scientific Data Images for Human/Mouse RIPK4/RIP4 Antibody
Detection of Human RIPK4/RIP4 by Western Blot.
Western blot shows lysates of A549 human lung carcinoma cell line, PANC-1 human pancreatic carcinoma cell line, and SK-OV-3 human ovarian adenocarcinoma cell line. PVDF membrane was probed with 2 µg/mL of Goat Anti-Human/Mouse RIPK4/RIP4 Antigen Affinity-purified Polyclonal Antibody (Catalog # AF10002) followed by HRP-conjugated Anti-Goat IgG Secondary Antibody (Catalog # HAF017). A specific band was detected for RIPK4/RIP4 at approximately 80 kDa (as indicated). This experiment was conducted under reducing conditions and using Immunoblot Buffer Group 1.RIPK4/RIP4 in Human Kidney.
RIPK4/RIP4 was detected in immersion fixed paraffin-embedded sections of human kidney using Goat Anti-Human/Mouse RIPK4/RIP4 Antigen Affinity-purified Polyclonal Antibody (Catalog # AF10002) at 0.3 µg/mL for 1 hour at room temperature followed by incubation with the Anti-Goat IgG VisUCyte™ HRP Polymer Antibody (Catalog # VC004). Before incubation with the primary antibody, tissue was subjected to heat-induced epitope retrieval using Antigen Retrieval Reagent-Basic (Catalog # CTS013). Tissue was stained using DAB (brown) and counterstained with hematoxylin (blue). Specific staining was localized to cytoplasm in cells in convoluted tubules. View our protocol for IHC Staining with VisUCyte HRP Polymer Detection Reagents.RIPK4/RIP4 in Mouse Kidney.
RIPK4/RIP4 was detected in perfusion fixed frozen sections of mouse kidney using Goat Anti-Human/Mouse RIPK4/RIP4 Antigen Affinity-purified Polyclonal Antibody (Catalog # AF10002) at 1 µg/mL for 1 hour at room temperature followed by incubation with the Anti-Goat IgG VisUCyte™ HRP Polymer Antibody (Catalog # VC004). Before incubation with the primary antibody, tissue was subjected to heat-induced epitope retrieval using Antigen Retrieval Reagent-Basic (Catalog # CTS013). Tissue was stained using DAB (brown) and counterstained with hematoxylin (blue). Specific staining was localized to cytoplasm in cells in convoluted tubules. View our protocol for IHC Staining with VisUCyte HRP Polymer Detection Reagents.Applications for Human/Mouse RIPK4/RIP4 Antibody
Immunohistochemistry
Sample: Immersion fixed paraffin-embedded sections of human kidney, and perfusion fixed frozen sections of mouse kidney
Western Blot
Sample: A549 human lung carcinoma cell line, PANC‑1 human pancreatic carcinoma cell line, and SK‑OV‑3 human ovarian adenocarcinoma cell line
Formulation, Preparation, and Storage
Purification
Reconstitution
Formulation
Shipping
Stability & Storage
- 12 months from date of receipt, -20 to -70 °C as supplied.
- 1 month, 2 to 8 °C under sterile conditions after reconstitution.
- 6 months, -20 to -70 °C under sterile conditions after reconstitution.
Background: RIPK4/RIP4
Receptor-interacting serine-threonine kinase 4 (RIPK4/PKK) is a serine/threonine protein kinase which interacts with protein kinase C-delta, but also activates NFkappaB, and interacts with the Wnt3a coreceptor LRP6 after Wnt3a stimulation. RIPK4 is required for keratinocyte differentiation and has broad expression in epithelial tissues. Down regulation of RIPK4 has been observed in squamous cell carcinomas, hepatocellular carcinoma, urothelial carcinoma and cervical carcinoma. Mutations in in the RIPK4 gene cause Popliteal pterygium syndrome, lethal type (PPS-L), CHAND syndrome and Bartsocas-Papas syndrome.
Long Name
Alternate Names
Gene Symbol
UniProt
Additional RIPK4/RIP4 Products
Product Documents for Human/Mouse RIPK4/RIP4 Antibody
Product Specific Notices for Human/Mouse RIPK4/RIP4 Antibody
For research use only